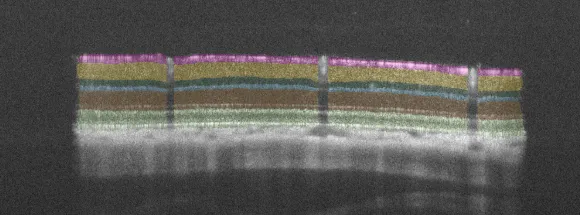

Disease models
Microbead-Induced Glaucoma
In 2011, Samsel and colleagues first described a magnetic microbead-induced elevated intraocular pressure (IOP) model, which was established by injecting magnetic microbeads into the anterior chamber of the eye. This model effectively simulates the gradual IOP elevation seen in glaucomatous neuropathies. The development of advanced in vivo imaging and functional assessment techniques has transformed this model into a reliable and widely used tool for studying the mechanisms of glaucoma and evaluating novel neuroprotective therapies. It closely replicates key aspects of optic nerve damage and retinal ganglion cell degeneration observed in human glaucoma.

Technical details
Mouse and rat
Intracameral injection of magnetic microbeads
Typically 28 days
– Quantitative evaluation of inner retinal layer thickness from SD-OCT scans using AI-driven algorithms
– Functional assessment of RGCs (pERG)
– Visual acuity and contrast sensitivity (OMR)
– Quantitative estimation of RGCs
Scientific excellence in every model
Chronic IOP elevation
One of the best models to mimic hypertensive glaucoma
Non-invasive monitoring of pathology
Application of 3Rs using in vivo imaging, functional assessment and behavioral analysis
Unbiased quantitative data
From functional to morphological readouts
References
- Samsel, P. A., Kisiswa, L., Erichsen, J. T., Cross, S. D., & Morgan, J. E. (2011). A novel method for the induction of experimental glaucoma using magnetic microspheres. Investigative ophthalmology & visual science, 52(3), 1671-1675.
- Tribble, J. R., Otmani, A., Kokkali, E., Lardner, E., Morgan, J. E., & Williams, P. A. (2021). Retinal ganglion cell degeneration in a rat magnetic bead model of ocular hypertensive glaucoma. Translational Vision Science & Technology, 10(1), 21-21.
Access model details
Interested to learn more? Submit the form, and we will provide tailored information on this model.
"*" indicates required fields
We are here to help
Whether you have a question about our preclinical models, capabilities, pricing or anything else, our team is ready to answer all your inquiries.
Related services
Visual Evoked Potentials
Visual evoked potential recording is used to assess visual pathway function from retina to cortex in models of glaucoma and optic neuropathies.
Learn moreAI for image analysis
AI-driven image analysis for in vivo studies, delivering faster, unbiased results and deeper insights for your preclinical ocular programs.
Learn moreOptomotor Reflex
Experimentica offers behavioral assessment and optomotor response testing to evaluate visual acuity and contrast sensitivity in rodent models.
Learn moreCheck out our latest news and activities
All News






